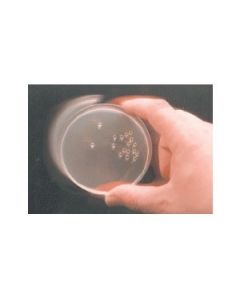
Millipore Plating Bead, 15 To 30deg C Storage Temperature

We use cookies to make your experience better. To comply with the new e-Privacy directive, we need to ask for your consent to set the cookies. Learn more.
Flow Cytometry Reagents
-
Millipore Plating Bead, 15 To 30deg C Storage Temperature (more info)
List Price $48.83 Your Price $48.83NETA PART: MILL-71013-3 MFG. PART: 71013-3 -

Millipore Colirollers Plating Beads 1pkg (more info)
List Price $149.33 Your Price $149.33NETA PART: MILL-71013-4 MFG. PART: 71013-4 -

Beckman DURAClone IM Count Tube, 25 tests, RUO (more info)
List Price $414.90 Your Price $414.90NETA PART: BCKM-C00162 MFG. PART: C00162 -

Beckman FLEXLyse 100ml RUO (more info)
List Price $846.30 Your Price $846.30NETA PART: BCKM-C54313 MFG. PART: C54313 -

Millipore Ready-To-Assay Mu Opioid Receptor Frozen Cells (more info)
List Price $994.08 Your Price $994.08NETA PART: MILL-HTS101RTA MFG. PART: HTS101RTA -

Cell Signaling Human Essential T Cell Markers Flow Cytometry Panel (more info)
List Price $1,256.44 Your Price $1,256.44NETA PART: CSIG-96708S MFG. PART: 96708S -

Cell Signaling Mouse Progenitor Exhausted Cd8+ T Cell Markers Flow Cytometry Panel (more info)
List Price $1,289.77 Your Price $1,289.77NETA PART: CSIG-60395S MFG. PART: 60395S -

Beckman Duraclone Im B Cells Tube, 25 Tests, Ruo (more info)
List Price $1,522.50 Your Price $1,522.50NETA PART: BCKM-B53318 MFG. PART: B53318 -

Beckman DURAClone IM Phenotyping BASIC Tube, 25 tests, RUO (more info)
List Price $1,522.50 Your Price $1,522.50NETA PART: BCKM-B53309 MFG. PART: B53309 -

Beckman DURAClone SC Mesenchymal Tube, 25 tests, RUO (more info)
List Price $1,632.00 Your Price $1,632.00NETA PART: BCKM-C34369 MFG. PART: C34369
